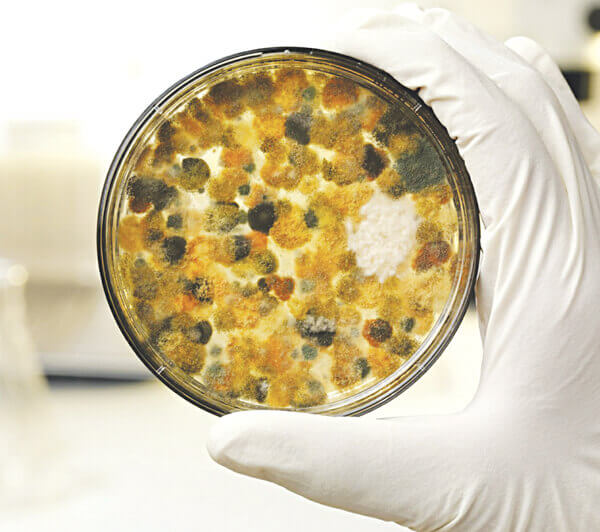
Nấm mốc, vi khuẩn tích tụ Nấm mốc, vi khuẩn tích tụ

Tác hại của máy rửa bát là chủ đề đang được nhiều người quan tâm, đặc biệt trong thời gian gần đây khi không ít chị em truyền tai nhau rằng thiết bị này có thể ảnh hưởng đến sức khỏe người sử dụng. Vậy thực hư ra sao? Liệu máy rửa bát có thực sự là “mối nguy” tiềm ẩn trong căn bếp hiện đại? Trong bài viết này, hãy cùng Kithome tìm hiểu chi tiết về nguyên nhân, mức độ rủi ro và cách phòng tránh tác hại của máy rửa bát để sử dụng thiết bị này một cách an toàn và hiệu quả nhất.
Thực trạng: Máy rửa bát và những lời “đồn” về tác hại

Từ những câu chuyện nhỏ trong các hội nhóm nội trợ đến các bài viết chia sẻ trên mạng, bạn có thể bắt gặp các “lời đồn” như:
-
“Máy rửa bát cứ dùng lâu – đồ bẩn đầu chưa sạch, đồ có mùi”
-
“Máy rửa bát gây nấm mốc trong khoang, rồi ảnh hưởng sức khỏe”
-
“Máy rửa bát thay vì tiện lại thành… loăng quăng vi khuẩn”
Điều này dẫn đến câu hỏi: liệu có đúng máy rửa bát gây hại như vậy không? Chúng ta sẽ đi sâu vào các nghiên cứu khoa học để tìm câu trả lời.
Nguyên lý hoạt động & vì sao có thể phát sinh “tác hại của máy rửa bát ”
Nguyên lý cơ bản
Máy rửa bát là thiết bị gia dụng hiện đại chuyên dùng để làm sạch bát đĩa, xoong nồi bằng cách sử dụng nước nóng, chất tẩy rửa (viên rửa hoặc bột), áp lực phun tia nước mạnh và chế độ sấy khô. Nhờ quy trình này, máy giúp loại bỏ hiệu quả thức ăn thừa, dầu mỡ và vi khuẩn. Khi hoạt động đúng cách, thiết bị mang lại nhiều lợi ích như: rửa sạch sâu, tiết kiệm nước, tiết kiệm thời gian và bảo vệ da tay cho người sử dụng.
Vì sao có thể phát sinh tác hại của máy rửa bát?
Dù có nguyên lý hoạt động hướng đến sự sạch sẽ và tiện lợi, song trong một số điều kiện không lý tưởng, tác hại của máy rửa bát có thể phát sinh do môi trường bên trong máy tạo điều kiện thuận lợi cho vi khuẩn và nấm mốc phát triển. Cụ thể:
-
Nhiệt độ cao kết hợp với độ ẩm ứ đọng khiến khoang máy rửa bát trở nên nóng và ẩm sau mỗi chu trình — môi trường lý tưởng cho vi sinh vật.
-
Thức ăn thừa hoặc vụn bám lại trên bát đĩa, tay phun hoặc đáy máy trở thành nguồn “dinh dưỡng” cho vi khuẩn, nấm mốc.
-
Các bộ phận như gioăng cao su, khay chứa, ống thoát nước thường khó vệ sinh, dễ bị tích tụ cặn bẩn và vi sinh vật nếu không làm sạch định kỳ.
-
Sự luân phiên giữa nóng‑ẩm và nguội‑khô tạo điều kiện để vi khuẩn hình thành màng sinh học (biofilm), làm giảm khả năng vệ sinh thực sự sạch.
-
Ngoài ra, nước cấp hoặc hệ thống ống dẫn có thể mang sẵn vi khuẩn từ bên ngoài vào máy.
Một nghiên cứu của Nina Gunde‑Cimerman và cộng sự khảo sát 30 máy rửa bát tại gia cho thấy: tất cả các máy đều có sự hiện diện của nhiều loại vi khuẩn, đặc biệt là ở các gioăng cao su cửa máy – nơi ẩm thấp và ít được vệ sinh. Giáo sư Erica Hartmann (Đại học Northwestern) cũng cảnh báo rằng: mặc dù máy rửa bát không trực tiếp gây hại với người khỏe mạnh, nhưng tác hại của máy rửa bát có thể ảnh hưởng đến những người có hệ miễn dịch yếu, vì môi trường trong máy là một môi trường “cực đoan” – vừa nóng, vừa ẩm, lại có dư lượng hóa chất.
Chính xác tác hại của máy rửa bát là gì? Phân tích kỹ hơn
Dưới đây là các “tác hại của máy rửa bát” có thể xảy ra khi sử dụng máy rửa bát – kèm theo phân tích mức độ và ai là người có rủi ro cao hơn.
Nấm mốc, vi khuẩn tích tụ
-
Nghiên cứu cho thấy trên gioăng cửa máy rửa bát có thể tìm thấy nhiều loại vi khuẩn và cả nấm như Candida, Cryptococcus, Rhodotorula…
-
Ví dụ: nghiên cứu tại Slovenia phát hiện 632 mẫu vi khuẩn từ 30 máy, thuộc 74 loài khác nhau, trong đó có cả các loài opportunistic pathogens (cơ hội bệnh tấn công người có miễn dịch yếu).
-
Nhưng: mặc dù có sự tồn tại của vi sinh vật, không có bằng chứng rõ ràng rằng máy rửa bát gây ra đại dịch hay lây nhiễm thường xuyên cho người khỏe mạnh. Như Hartmann nói: “Rủi ro trong khoảng như tấn công cá mập” (cực thấp) nếu bạn khỏe mạnh.
-
Vì vậy: tác hại thực sự không phải là một điều chắc chắn sẽ xảy ra — nó là khả năng tăng lên khi máy không vệ sinh tốt hoặc sử dụng không đúng.
Mùi hôi, cảm giác không sạch
Một trong những tác hại của máy rửa bát thường gặp nhất là xuất hiện mùi hôi và cảm giác bát đĩa “chưa sạch” sau khi rửa. Hiện tượng này thường xảy ra khi trong máy bị tích tụ thức ăn thừa, dầu mỡ hoặc không được vệ sinh định kỳ. Khi đó, khoang máy dễ phát sinh mùi khó chịu, bề mặt bát đĩa có thể còn vệt bẩn hoặc lớp màng mỏng, khiến người dùng cảm thấy không yên tâm khi sử dụng.
Tình trạng này không chỉ làm giảm trải nghiệm nấu nướng mà còn cho thấy tác hại của máy rửa bát nếu bảo dưỡng sai cách – môi trường ẩm và bẩn bên trong máy sẽ tạo điều kiện thuận lợi cho vi khuẩn, nấm mốc phát triển, ảnh hưởng đến chất lượng vệ sinh bát đĩa và sức khỏe gia đình.
Tác hại của máy rửa bát với người có hệ miễn dịch yếu
Một trong những tác hại của máy rửa bát ít được chú ý nhưng có thể ảnh hưởng nghiêm trọng là nguy cơ gây nhiễm khuẩn đối với người có hệ miễn dịch suy giảm. Cụ thể, các đối tượng như người cao tuổi, trẻ nhỏ, người mắc bệnh mãn tính, bệnh phổi hoặc đang trong quá trình hồi phục sau ốm có thể dễ bị ảnh hưởng bởi vi khuẩn, nấm mốc tồn tại trong môi trường máy rửa bát – đặc biệt nếu máy không được vệ sinh đúng cách.
Một số nghiên cứu đã ghi nhận rằng máy rửa bát có thể trở thành nguồn tiềm năng cho các tác nhân gây nhiễm trùng đối với nhóm người có miễn dịch kém. Trong khi đó, với người khỏe mạnh, việc sử dụng máy rửa bát đúng cách vẫn rất an toàn và tiện lợi. Tuy nhiên, để hạn chế tối đa tác hại của máy rửa bát, những gia đình có thành viên thuộc nhóm nhạy cảm này nên đặc biệt cẩn trọng trong việc bảo dưỡng và vệ sinh thiết bị thường xuyên.
Hiệu quả rửa kém & cảm giác không an toàn – một dạng tác hại của máy rửa bát
Một trong những tác hại của máy rửa bát mà người dùng thường gặp phải chính là hiệu quả rửa không như kỳ vọng, tạo cảm giác bát đĩa vẫn còn bẩn hoặc không an toàn khi sử dụng. Nguyên nhân có thể đến từ việc không vệ sinh máy định kỳ, lọc bị tắc, ống thoát nước hoạt động kém, nhiệt độ nước không đủ cao hoặc xếp đồ sai cách khiến tia nước không phun đều.
Những yếu tố này khiến máy hoạt động kém hiệu quả, dẫn đến tình trạng bát đĩa còn cặn bẩn, dầu mỡ hoặc mùi khó chịu, khiến người dùng cảm thấy máy rửa bát kém hơn rửa tay. Tuy nhiên, thực tế cho thấy nếu sử dụng đúng cách, vệ sinh định kỳ và tuân thủ hướng dẫn, máy rửa bát hiện đại hoàn toàn có thể rửa sạch sâu và sấy khô tốt hơn so với rửa tay thủ công — đồng thời đảm bảo an toàn vệ sinh hơn rất nhiều.
Có nên lo lắng với tác hại của máy rửa bát không?
Tác hại của máy rửa bát là điều hoàn toàn có thể xảy ra, nhưng chỉ khi người dùng sử dụng sai cách hoặc bỏ qua việc vệ sinh, bảo dưỡng thiết bị thường xuyên. Trong điều kiện sử dụng đúng, máy rửa bát không phải là thiết bị nguy hiểm. Ngược lại, nó mang lại rất nhiều tiện ích vượt trội như làm sạch sâu, tiết kiệm nước, bảo vệ da tay và diệt khuẩn hiệu quả.
Trên thực tế, tác hại của máy rửa bát chủ yếu xuất hiện khi môi trường bên trong máy không được làm sạch định kỳ, tạo điều kiện cho vi khuẩn, nấm mốc phát triển và bám lại trên bát đĩa. Điều này hoàn toàn có thể phòng tránh được nếu bạn sử dụng đúng hướng dẫn và vệ sinh máy định kỳ.
Với người khỏe mạnh, rủi ro về sức khỏe do máy rửa bát gây ra là rất thấp. Tuy nhiên, nếu bạn hoặc người thân thuộc nhóm có hệ miễn dịch yếu như trẻ nhỏ, người già hoặc người bệnh mãn tính, hãy đặc biệt lưu ý đến việc làm sạch máy, kiểm tra định kỳ và sử dụng chế độ rửa, sấy phù hợp để hạn chế tối đa mọi nguy cơ tiềm ẩn.
Cách hạn chế & sử dụng máy rửa bát an toàn hiệu quả
Để tận dụng ưu điểm của máy rửa bát mà giảm thiểu những tác hại của máy rửa bát bạn nên thực hiện các bước sau:
Vệ sinh máy rửa bát thường xuyên cả bên ngoài và bên trong

-
Lau sạch thân máy, cửa máy, và phần cao su gioăng cửa.
-
Vệ sinh bên trong máy, chú ý tới: khoang chứa đồ, tay phun nước, khoang đáy, ống thoát, lọc rác.
-
Với các vị trí như lỗ cao su thoát thức ăn, bạn nên dùng bàn chải nhỏ với dung dịch nước ấm + giấm + baking soda (hoặc chất tẩy nhẹ) để chải sạch.
-
Định kỳ cho máy chạy chu trình trống với nước nóng hoặc chế độ “tự làm sạch” nếu có để “rửa nội bộ” máy.
Loại bỏ thức ăn thừa trên bát đĩa trước khi cho vào máy

-
Trước khi xếp bát đĩa vào máy, bạn nên loại bỏ hết thức ăn thừa và vụn bằng cách tráng sơ hoặc dùng khăn giấy nén qua – tránh để thức ăn bám lại trong khoang máy hoặc ống thoát.
-
Xếp bát đĩa gọn vào khay rửa, không xếp quá chồng, đảm bảo tia nước phun vào đều.
Kiểm tra và loại bỏ thức ăn thừa sau mỗi lần sử dụng – cách hạn chế tác hại của máy rửa bát
Để hạn chế tác hại của máy rửa bát, việc kiểm tra và làm sạch bên trong máy sau mỗi lần sử dụng là vô cùng cần thiết. Sau khi kết thúc chu trình rửa, bạn nên quan sát kỹ phần đáy máy và khay lọc để phát hiện kịp thời các vụn thức ăn hoặc cặn bẩn bị mắc kẹt. Đây là những nguyên nhân phổ biến gây mùi hôi, giảm hiệu quả làm sạch và tạo điều kiện cho vi khuẩn, nấm mốc sinh sôi.
Nếu phát hiện dầu mỡ bám lại hoặc có mùi khó chịu, bạn có thể cho một ít nước cốt chanh hoặc giấm vào ngăn chứa xà phòng, sau đó chạy một chu trình ngắn ở nhiệt độ cao. Cách này giúp “sát trùng” máy hiệu quả, loại bỏ mùi hôi và giữ khoang máy luôn khô ráo, sạch sẽ – từ đó giảm thiểu đáng kể nguy cơ phát sinh các tác hại của máy rửa bát trong quá trình sử dụng lâu dài.
Chạy chu trình nhiệt độ cao, sấy khô và thông gió – Cách hạn chế tác hại của máy rửa bát
Để giảm thiểu tác hại của máy rửa bát, bạn nên tận dụng tối đa các chức năng diệt khuẩn mà thiết bị cung cấp. Nếu máy có chế độ sấy khô và diệt khuẩn bằng nhiệt, hãy kích hoạt chế độ này sau mỗi chu trình để đảm bảo bát đĩa được tiệt trùng, giảm thiểu vi khuẩn và nấm mốc.
Ngoài ra, hãy đảm bảo máy được lắp đặt ở nơi thoáng khí, không ẩm thấp, và sau khi máy hoàn tất quá trình rửa, bạn nên mở hé cửa máy trong 10–15 phút để giải phóng hơi nước, tránh môi trường kín ẩm – vốn là điều kiện thuận lợi cho vi khuẩn phát triển, gây ra nhiều tác hại tiềm ẩn của máy rửa bát.
Thay lọc, kiểm tra ống thoát nước và gioăng cao su định kỳ
Một nguyên nhân phổ biến dẫn đến tác hại của máy rửa bát là do người dùng bỏ qua việc vệ sinh các bộ phận kỹ thuật như lọc rác, ống thoát nước hoặc gioăng cao su.
-
Lọc rác và lưới lọc ở đáy máy nên được tháo ra và rửa sạch định kỳ (1–2 tuần/lần), để tránh tích tụ thức ăn thừa gây mùi hoặc làm giảm hiệu suất rửa.
-
Gioăng cao su cửa máy là nơi thường xuyên tiếp xúc với nước và cặn bẩn, nếu không được lau khô sẽ dễ lên mốc, phát sinh mùi hôi. Sau mỗi lần sử dụng, nên dùng khăn khô lau sạch toàn bộ viền cao su này.
-
Ống thoát nước cần kiểm tra xem có bị gấp khúc, tắc nghẽn hoặc nước đọng ngược hay không. Những tình trạng này không chỉ gây mùi mà còn làm giảm tuổi thọ của máy.
Khi nào cần đặc biệt cẩn trọng với tác hại của máy rửa bát?
Một số trường hợp đòi hỏi bạn phải nâng cao cảnh giác và chăm sóc máy kỹ hơn để tránh những tác động tiêu cực không mong muốn:
-
Nếu trong gia đình có người cao tuổi, trẻ nhỏ, người đang ốm hoặc có hệ miễn dịch yếu, hãy đặc biệt chú trọng vệ sinh máy mỗi ngày, và nếu cần thiết, có thể rửa riêng bát đĩa của họ bằng tay hoặc chế độ riêng biệt, đặc biệt khi máy có dấu hiệu chưa được bảo dưỡng tốt.
-
Nếu máy rửa bát đã sử dụng lâu năm, bạn cần theo dõi các dấu hiệu cảnh báo như:
-
Gioăng cao su bị nứt, mục
-
Máy bốc mùi rất khó chịu dù đã rửa sạch
-
Ống thoát nước thường xuyên bị tắc hoặc nước chảy ngược
=> Đây là thời điểm bạn nên cân nhắc bảo dưỡng chuyên sâu hoặc thay thế máy mới để đảm bảo an toàn cho sức khỏe và hiệu quả sử dụng.
-
Ưu điểm của máy rửa bát khi sử dụng đúng cách
Mặc dù có một số cảnh báo về tác hại của máy rửa bát nếu sử dụng sai cách, nhưng thực tế cho thấy khi được dùng đúng và vệ sinh thường xuyên, thiết bị này mang lại rất nhiều lợi ích vượt trội:
-
Làm sạch sâu hơn so với rửa tay: Máy rửa bát sử dụng tia nước áp lực cao, kết hợp nước nóng từ 70–82 °C và viên rửa chuyên dụng giúp loại bỏ hoàn toàn dầu mỡ, mảng bám cứng đầu trên bát đĩa, xoong nồi.
-
Diệt khuẩn và sấy khô hiệu quả: Nhiều dòng máy hiện đại tích hợp chế độ sấy khô bằng nhiệt cao (lên tới 100 °C), giúp bát đĩa không chỉ sạch mà còn khô ráo, hạn chế sự phát triển của vi khuẩn và nấm mốc.
-
Tiết kiệm nước và điện: Trong khi rửa tay cho một bữa ăn gia đình 4–5 người có thể tiêu tốn tới 15–20 lít nước, thì máy rửa bát hiện đại chỉ cần khoảng 10–15 lít nhờ công nghệ cảm biến và tuần hoàn nước thông minh. Ngoài ra, nhiều dòng máy còn tích hợp công nghệ Inverter giúp tiết kiệm điện năng đáng kể.
-
Tiết kiệm thời gian và công sức: Bạn chỉ cần mất vài phút để xếp bát đĩa vào máy, chọn chế độ phù hợp, rồi hoàn toàn rảnh tay để dành thời gian cho bản thân, con cái hoặc công việc khác.
-
An toàn hơn cho người sử dụng: Sử dụng máy rửa bát đúng cách giúp giảm tiếp xúc trực tiếp với nước nóng, hóa chất rửa chén và các vật sắc nhọn như dao kéo, từ đó hạn chế rủi ro bỏng, trượt ngã hoặc đứt tay khi rửa tay truyền thống.
Gợi ý khi chọn mua và sử dụng máy rửa bát để tránh tác hại
Để phát huy tối đa lợi ích và hạn chế các tác hại của máy rửa bát, bạn nên lưu ý các điểm sau khi chọn mua và sử dụng:
-
Ưu tiên máy có chế độ sấy khô và diệt khuẩn bằng nhiệt độ cao, đặc biệt phù hợp với gia đình có trẻ nhỏ hoặc người có hệ miễn dịch yếu.
-
Chọn thiết kế dễ vệ sinh: Khoang máy nên dễ lau chùi, có lọc rác lớn, gioăng cao su dễ tháo rời và làm sạch để ngăn ngừa vi khuẩn tích tụ.
-
Tìm máy có chế độ tự làm sạch: Một số dòng máy hiện đại có chế độ tự vệ sinh định kỳ, giúp hạn chế tích tụ dầu mỡ và thức ăn thừa trong khoang máy.
-
Đặt máy ở nơi khô ráo, thông thoáng, tránh khu vực ẩm ướt hoặc quá kín – giúp hạn chế vi khuẩn sinh sôi và kéo dài tuổi thọ thiết bị.
-
Đọc kỹ hướng dẫn sử dụng trước khi vận hành, đặc biệt là phần vệ sinh và bảo dưỡng máy định kỳ – đây là yếu tố quan trọng để hạn chế tối đa mọi tác hại của máy rửa bát trong quá trình sử dụng lâu dài.
-
Xếp bát đĩa hợp lý, loại bỏ thức ăn thừa trước khi cho vào máy, và chỉ dùng viên/bột rửa chuyên dụng được khuyến nghị từ nhà sản xuất để đảm bảo hiệu quả tối ưu và độ bền của thiết bị.
Tác hại của máy rửa bát sẽ không nguy hiểm nếu bạn sử dụng và bảo dưỡng đúng cách. Thực tế là, môi trường bên trong máy rửa bát có thể tạo điều kiện cho vi khuẩn và nấm phát triển — nhưng mức độ rủi ro đối với người khỏe mạnh là rất thấp. Điều then chốt nằm ở việc bạn sử dụng cách nào: vệ sinh định kỳ, loại bỏ thức ăn thừa, xếp đồ đúng cách, và kiểm tra máy thường xuyên.
Nếu bạn thực hiện được những điều trên, bạn sẽ tận dụng được tất cả lợi ích của máy rửa bát: rửa sạch hơn, tiết kiệm hơn, an toàn hơn và đem lại cảm giác nhẹ nhàng hơn sau mỗi bữa ăn.
Để biết thêm thông tin chi tiết và đặt hàng sản phẩm, hãy liên hệ ngay với Kithome. Chúng tôi luôn sẵn sàng hỗ trợ bạn!
Hotline: 0983 196 190
Website: kithome.com.vn | bepkithome.vn
Địa chỉ: Liền kề 11 – Lô A17 KĐT Geleximco, An Khánh, Hoài Đức, Hà Nội
Fanpage: Kithome Hà Nội
YouTube: Bếp Kithome Official
TikTok: @thuongpham9190
Zalo OA: Kithome Zalo
Hãy đến với Kithome để trải nghiệm sản phẩm và dịch vụ tốt nhất!

